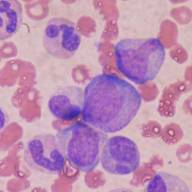
Researchers find new, safer treatment for serious side effect of bone marrow transplant

Todos

Identifican una posible estrategia terapéutica para tratar el glioblastoma
Jueves, 11 Diciembre 2025 01:50

Localizan un 'sensor renal' que ayuda al organismo a controlar la presión arterial y los líquidos
Jueves, 11 Diciembre 2025 01:31

Investigadores identifican un mecanismo inmunológico clave que podría reducir la inflamación crónica en la cirrosis hepática
Jueves, 11 Diciembre 2025 01:18

Una simple muestra de orina podría transformar el diagnóstico del cáncer de vejiga
Jueves, 11 Diciembre 2025 01:06El cáncer de vejiga es una enfermedad de difícil gestión. Además de su elevada prevalencia, presenta tasas muy altas de recurrencia, lo que obliga a los pacientes a someterse repetidamente a...

Describen un tipo de muerte celular programada, ferroptosis, en los hepatocitos del hígado viejo
Miércoles, 03 Julio 2024 00:11

El Ministerio de Sanidad aprueba la financiación de Xenpozyme® (olipudasa alfa) para el tratamiento de ASMD
Martes, 07 Mayo 2024 00:29

A promising drug candidate for ALS prolongs lifespan and eases symptoms in rats and mice
Viernes, 22 Septiembre 2023 19:24A research group at the University of Helsinki and its partners have found a promising drug candidate for the treatment of amyotrophic lateral sclerosis (ALS). Cerebral dopamine neurotrophic...

Key regulators involved in genesis of multiple sclerosis lesions identified
Viernes, 22 Septiembre 2023 18:19

Exercise and muscle regulation: Implications for diabetes and obesity
Miércoles, 20 Septiembre 2023 19:54

Non-alcoholic fatty liver disease: Hepatokines mediate its impact on metabolic diseases and help to identify subtypes
Martes, 07 Febrero 2023 17:42

Un nuevo mecanismo de muerte celular podría ofrecer nuevas estrategias de tratamiento del cáncer
Martes, 07 Febrero 2023 07:30

Encuentran un fármaco prometedor para el tratamiento del hígado graso no alcohólico
Lunes, 06 Febrero 2023 14:56

La fractalquina promueve la remielinización en el sistema nervioso central
Viernes, 03 Febrero 2023 20:52

Study identifies features that may make motor neurons vulnerable to ALS
Jueves, 02 Febrero 2023 12:49

Un simple análisis de orina podría revelar la enfermedad de Alzheimer en su fase inicial
Viernes, 30 Diciembre 2022 21:12

Drug discovery offers potential treatment for common kidney disease
Miércoles, 14 Diciembre 2022 18:58

New study reveals hidden genetic anomaly behind common late-onset cerebellar ataxia
Miércoles, 14 Diciembre 2022 18:47
Researchers find new, safer treatment for serious side effect of bone marrow transplant
Miércoles, 14 Diciembre 2022 16:54

CRISPR technology improves Huntington's disease symptoms in models
Miércoles, 14 Diciembre 2022 09:04

Driver of cystic fibrosis lung inflammation yields target for treatment
Martes, 13 Diciembre 2022 18:51

Researchers identify key metabolic regulators of drug resistance in the fight against pancreatic cancer
Martes, 13 Diciembre 2022 17:09

Study highlights the role of astrocytes in the synaptic regulation of VTA dopamine neurons
Lunes, 12 Diciembre 2022 18:58

Un estudio amplía a 5 las variantes genéticas raras relacionadas con Alzheimer
Viernes, 09 Diciembre 2022 09:25

Brain plasticity study: Oxytocin drives development of neural connections in adult-born neurons
Jueves, 08 Diciembre 2022 15:16

Nuevo biomarcador para detectar precozmente placa arteriosclerótica en diabetes tipo 1
Miércoles, 07 Diciembre 2022 08:00

Researchers discover crucial role of brain's striatum cilia in time perception
Jueves, 01 Diciembre 2022 22:58

Identifying optimal blood tests for the development of new Alzheimer's therapies
Jueves, 01 Diciembre 2022 21:50

Una mutación genética podría explicar la acumulación de placas en el cerebro en la enfermedad de Alzheimer
Jueves, 01 Diciembre 2022 07:43

Biomarker in urine could be the first to reveal early-stage Alzheimer's disease
Miércoles, 30 Noviembre 2022 11:42

Constatan la implicación del inflamosoma en la autoinmunidad, las enfermedades cardíacas y en la neurodegeneración
Martes, 29 Noviembre 2022 10:17

Nueva herramienta, capaz de eliminar genes defectuosos y reemplazarlos por otros nuevos
Martes, 29 Noviembre 2022 00:00

Las células inmunitarias de pacientes con ELA pueden predecir el curso de la enfermedad
Lunes, 28 Noviembre 2022 14:53

Investigadores españoles señalan un nuevo marcador relacionado con el mal funcionamiento del sistema glinfático
Lunes, 28 Noviembre 2022 10:40


